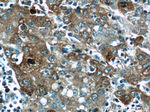
P62/SQSTM1 Antibody in Immunohistochemistry (Paraffin) (IHC (P))

Search
Proteintech
P62/SQSTM1 Polyclonal Antibody
{{$productOrderCtrl.translations['antibody.pdp.commerceCard.promotion.promotions']}}
{{$productOrderCtrl.translations['antibody.pdp.commerceCard.promotion.viewpromo']}}
{{$productOrderCtrl.translations['antibody.pdp.commerceCard.promotion.promocode']}}: {{promo.promoCode}} {{promo.promoTitle}} {{promo.promoDescription}}. {{$productOrderCtrl.translations['antibody.pdp.commerceCard.promotion.learnmore']}}
产品信息
18420-1-AP
种属反应
已发表种属
宿主/亚型
分类
类型
抗原
偶联物
形式
浓度
规格
纯化类型
保存液
内含物
保存条件
运输条件
产品详细信息
The molecular weight of p62 is predicted to be 48/ 38 kDa (depending on the isoform), while western blot analyses using this antibody detects the bands around 45-48 kDa and 60-62 kDa, respectively.
Immunogen sequence: MASLTVKAY LLGKEDAARE IRRFSFCCSP EPEAEAEAAA GPGPCERLLS RVAALFPALR PGGFQAHYRD EDGDLVAFSS DEELTMAMSY VKDDIFRIYI KEKKECRRDH RPPCAQEAPR NMVHPNVICD GCNGPVVGTR YKCSVCPDYD LCSVCEGKGL HRGHTKLAFP SPFGHLSEGF SHSRWLRKVK HGHFGWPGWE MGPPGNWSPR PPRAGEARPG PTAESASGPS EDPSVNFLKN VGESVAAALS PLGIEVDIDV EHGGKRSRLT PVSPESSSTE EKSSSQPSSC CSDPSKPGGN VEGATQSLAE QMRKIALESE GRPEEQMESD NCSGGDDDWT HLSSKEVDPS TGELQSLQMP ESEGPSSLDP SQEGPTGLKE AALYPHLPPE ADPRLIESLS QMLSMGFSDE GGWLTRLLQT KNYDIGAALD TIQYSKHPPP L (1-440 aa encoded by BC017222)
靶标信息
This gene encodes a multifunctional protein that binds ubiquitin and regulates activation of the nuclear factor kappa-B signaling pathway. The protein functions as a scaffolding/adaptor protein in concert with TNF receptor-associated factor 6 to mediate activation of NF-kB in response to upstream signals. Alternatively spliced transcript variants encoding either the same or different isoforms have been identified for this gene. Mutations in this gene result in sporadic and familial Paget disease of bone.
仅用于科研。不用于诊断过程。未经明确授权不得转售。
生物信息学
蛋白别名: autophagy receptor p62; EBI3-associated protein of 60 kDa; EBI3-associated protein p60; EBIAP; oxidative stress induced; oxidative stress induced like; p62; p62 transcript variant 4; p62 transcript variant 5; phosphotyrosine independent ligand for the Lck SH2 domain p62; Phosphotyrosine-independent ligand for the Lck SH2 domain of 62 kDa; PKC-zeta-interacting protein; Protein kinase C-zeta-interacting protein; Sequestosome-1; STONE14; Ubiquitin-binding protein p62; unnamed protein product
基因别名: A170; DMRV; EBIAP; FTDALS3; NADGP; ORCA; OSF-6; Osi; OSIL; p60; p62; p62B; PDB3; SQSTM1; STAP; STONE14; ZIP; ZIP3
UniProt ID: (Human) Q13501, (Rat) O08623, (Mouse) Q64337
Entrez Gene ID: (Human) 8878, (Rat) 113894, (Mouse) 18412